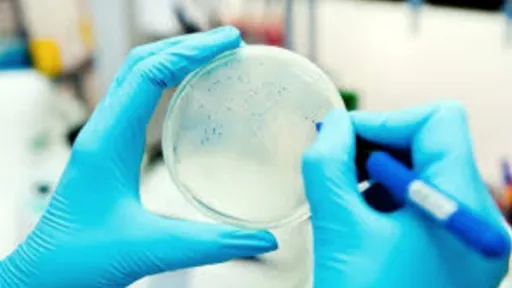

De la descoperirea lor, antibioticele au fost considerate drept piatra de temelie a medicinei moderne. Cu toate acestea, suprasolicitarea şi folosirea abuzivă a antibioticelor, a încurajat apariţia şi răspândirea rezistenţei la antibiotice în rândul oamenilor, dar și a animalelor. În acest an, întreaga omenire va marca cea de-a patra Săptămână mondială de conștientizare a rezistenței la antibiotice, în perioada 12-18 noiembrie 2018, angajându-se să aplice principiul „O singură sănătate pentru toți”.
Rezistența la antibiotice reprezintă o amenințare tot mai mare la adresa sănătății publice. Ca urmare a infecțiilor cauzate de bacteriile rezistente la diferite medicamente, la nivel mondial se înregistrează circa 700.000 de decese anual, iar aproximativ 33.000 de persoane decedează în Uniunea Europeană în fiecare an, din această cauză.Republica Moldova se găseşte într-o situație alarmantă la compartimentul reținerii rezistenței antimicrobiene, fapt ce impune necesitatea unor măsuri de intervenţie de maximă urgenţă la toate nivelurile. Sondajele „Eurobarometru” privind rezistența antimicrobiană, efectuate din 2010 și până în prezent, arată că nivelul de conștientizare, atât al specialiștilor din domeniu, cât a populației față de legătura dintre utilizarea antimicrobienelor, dezvoltarea și răspândirea rezistenței antimicrobiene continuă să fie scăzut. Aceasta duce în continuare la utilizarea irațională a antimicrobienelor la om și animale.La etapa actuală, oriunde în lume, antibioticele sunt utilizate pe scară largă în producția animalieră, aceleași clase de antimicrobiene fiind utilizate atât la om, cât și la animalele de la ferme, iar lanțul alimentar reprezintă o cale importantă pentru răspândirea microorganismelor rezistente la antimicrobiene. Multe dintre aceste microorganisme afectează atât animalele, cât și oamenii prin mediul pe care îl împart. Aceasta face ca sănătatea umană, animală și a mediului să fie inseparabilă atunci când vine vorba de combaterea rezistenței antimicrobiene, iar abordarea „O singură sănătate pentru toți” este singurul mod viabil de a face progrese reale în regiune și în lume.„Rezistența la antibiotice reprezintă o problemă majoră de sănătate publică, sporind de la an la an, numărul deceselor din cauza eșecului terapeutic. Pentru combaterea eficientă a acestui fenomen este necesară implicarea tuturor autorităților din sectorul sănătății umane dar și animale, siguranței alimentelor și furajelor, protecției mediului, industriei de producere și cercetare a medicamentelor, înregistrării produselor biologic active, administrațiilor publice centrale și locale, instituțiilor și departamentelor, organizațiilor necomerciale și societății civile per ansamblu. Comunicarea trebuie să ducă la creșterea gradului de conștientizare publică și profesională a rezistenței antimicrobiene, la prescrierea corectă și utilizarea rațională a antimicrobienelor”, a declarat secretarul de stat, Aliona Serbulenco.„Agenția pentru Siguranța Alimentelor, medicii veterinari asigurăm și supraveghem respectarea cadrului legislativ și normativ privind utilizarea antibioticelor în produsele de origine animalieră. Efectuăm ample programe de testare a laptelui, cărnii, peștelui, privind conținutul de reziduuri de antimicrobiene pentru a împiedica pătrunderea acestora pe piața de consum și de a evita impactul lor negativ asupra sănătățiii umane”, a menționat Gheorghe Gaberi, directorul Agenției Naționale pentru Siguranța Alimentelor.„Succesul în combaterea rezistenței la antibiotice rezidă în implicarea fiecărei persoane, medic clinician și veterinar, comunității și a societății în general”, a accentuat coordinatorul Programe urgențe în sănătate publică, Biroul OMS în Republica Moldova, Stela Gheorghiță.În același timp, rezultatele naționale privind sensibilitatea la antimicrobiene a microorganismelor patogene izolate de la persoane atestă o rezistență îngrijorătoare faţă de preparatele incluse în protocoalele naționale pentru terapia de primă intenție:• Fiecare a treia tulpină de Staphylococcus aureus este rezistentă la tetraciclină (30,4%), clindamicină (35,2%) și eritromicină (38,4%).• Aproximativ două din trei tulpini de Streptococcus pneumonia sunt rezistente la co-trimoxazol (59,6%), cefaclor (61,3%), oxacilină (64,9%).• Reprezentanții familiei Enterobacteriacea, precum E.coli, au prezentat rezistenţă îngrijorătoare la amoxicilin-clavulanic (56,5%), ampicilină (58,2%), aztreonam (62,0%), ticarcilin (72,6%).• Tuberculoza multidrogrezistență primară și secundară înregistrează rate înalte, respectiv comparativ cu media din Regiunea Europeană a OMS, constituind 26% și 64% comparativ cu 12% și 50% respectiv.• Circa 60% din tulpinile de microorganisme izolate de la pacienţi cu infecţii de plagă chirurgicală sunt rezistente la antimicrobiene.• Tratamentul medicamentos în boli obişnuite, precum faringite, bronşite sau toxiinfecţii alimentare cauzate de bacterii suferă eşec datorită administrării iraționale și, deseori, în exces a antimicrobienelor.Actualmente, la nivel național există cadrul legal privind modul de prescriere și eliberare a antibioticelor. Ministerul Sănătății, Muncii și Protecției Sociale întreprinde acțiuni pentru implementarea prevederilor privind eliberarea antimicrobienelor doar în baza prescrierii, ceea ce permite scăderea consumului de antibiotice, monitorizarea eliberării preparatelor și sancționarea abaterilor.În contextul Săptămânii Mondiale de Conștientizare a Rezistenței la Antibiotice în mai multe instituții medicale și instituții de învățământ din țară vor fi organizate diverse activități de informare și sensibilizare privind rezistența la antibiotice.Câteva reguli privind administrarea corectă a antibioticelor:• Utilizați antibioticele numai la prescrierea medicului.• Nu cereți antibiotice în cazul în care medicul spune că nu aveți nevoie de ele.• Întotdeauna urmați sfatul medicului atunci când utilizați antibioticele.• Nu folosiți antibioticele rămase în urma unui alt tratament.• Preveniți infecțiile prin spălarea frecventă pe mâini, folosirea alimentelor sigure, evitarea contactului cu persoanele bolnave și efectuarea vaccinării la timp.